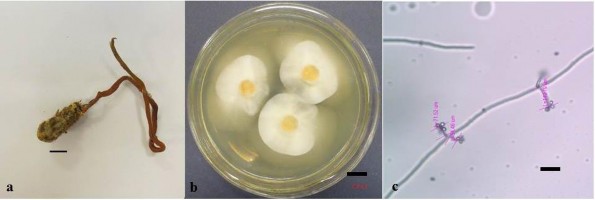
Hình 3 2 Hình thái mẫu CPA3 a Phần stroma b Khuẩn lạc nuôi cấy trên môi 3

Thí nghiệm sau khảo sát | |
chế hoạt chất. | (CD) |
Bước 3: Chiết phân lớp với các dung môi với độ phân cực tăng dần. Cụ thể, bổ sung 0,05 lít nước vào cao chiết CCM, lần lượt chiết phân lớp CCM với n-hexane, dichloromethane và ethyl acetate. Sau khi đuổi dung môi thu được cao chiết n-hexane (CCH), dichloromethane (CCD), ethyl acetate (CCE) và nước (CCN) tương ứng. | Bước 3: Bổ sung 0,05 lít nước vào cao chiết tổng dichloromethane (CD), sau đó chiết phân lớp với n-hexane. Sau khi đuổi dung môi thu được cao chiết n-hexane (CCH) và cao chiết dichloromethane (CCD). |
Bước 4: Cao chiết dichloromethane (CCD) được phân tách trên cột hấp phụ silica gel với hệ dung môi CH2Cl2:MeOH (từ 99:1 đến 1:1) thu được các phân đoạn nhỏ. Kiểm tra các phân đoạn nhỏ bằng sắc ký lớp mỏng và so sánh với chất chuẩn COD | Bước 4: Cao chiết dichloromethane (CCD) hòa tan hoàn toàn và tẩm silicagel cho tới khi tạo thành hỗn hợp bột khô, mịn với tỷ lệ silica gel/cao chiết là 2,5/1 (g/g). Sau đó được tiến hành sắc ký qua cột silica gel (sắc ký cột được thực hiện với cột dài 60cm, đường kính cột 3.0 cm, silicagel Merck 0,063-0,200 mm), với hệ dung môi CH2Cl2:MeOH (từ 99:1 đến 20:1). Dung dịch rửa giải thu được từ cột silica gel khoảng cách mỗi lần là 100ml-200ml, sau đó cất lại dung môi thu được những phân đoạn nhỏ 5-10ml ta được các phân đoạn. Kiểm tra các phân đoạn nhỏ bằng sắc ký lớp mỏng và so sánh với chất chuẩn COD, sau đó dồn những phân đoạn giống nhau lại, ta thu được các phân đoạn chính. |
Bước 5: Phân đoạn được lựa chọn sau bước 4 tiếp tục được phân tách trên cột pha đảo RP-18 với hệ dung môi MeOH:H2O (3:7) thu được các | Bước 5: Phân đoạn được lựa chọn sau bước 4 tiếp tục được phân tách trên cột pha đảo RP-18 với hệ dung môi MeOH:H2O (3:7) thu được các phân |
Có thể bạn quan tâm!
-
Tách Chiết, Tinh Sạch Và Nghiên Cứu Cấu Trúc Cyclooligomer Depsipeptide Từ Nấm Ký Sinh Côn Trùng -
Phương Pháp Tuy N Chọn Chủng Nấm Sinh Cyclooligomer Depsipeptide -
Đánh Giá Hoạt Tính Gây Độc Tế Bào Theo Phương Pháp Mtt -
Nghiên cứu đa dạng và sinh tổng hợp Cyclooligomer depsipeptide của nấm ký sinh côn trùng tại Khu Bảo tồn thiên nhiên Copia và Vườn quốc gia Xuân Sơn - 10 -
Nghiên cứu đa dạng và sinh tổng hợp Cyclooligomer depsipeptide của nấm ký sinh côn trùng tại Khu Bảo tồn thiên nhiên Copia và Vườn quốc gia Xuân Sơn - 11 -
Định Loại Phân Tử Các Chủng Nấm Ký Sinh Côn Trùng Đ Phân Lập Ở Khu Vực Nghiên Cứu
Xem toàn bộ 228 trang tài liệu này.
Thí nghiệm sau khảo sát | |
phân đoạn nhỏ. Kiểm tra các phân đoạn nhỏ bằng sắc ký lớp mỏng và so sánh với chất chuẩn COD. | đoạn nhỏ. Kiểm tra các phân đoạn nhỏ bằng sắc ký lớp mỏng và so sánh với chất chuẩn COD. |
Bước 6: Phân đoạn được lựa chọn sau bước 5 được tinh chế lại qua cột sephadex LH20 với dung môi rửa giải MeOH | Bước 6: Tinh chế phân đoạn được chọn qua cột sephadex LH20 với dung môi rửa giải MeOH thu được các phân đoạn nhỏ. Kiểm tra các phân đoạn nhỏ bằng sắc ký lớp mỏng và so sánh với chất chuẩn COD. |
Bước 7: Kết tinh trong dung môi acetone thu được hợp chất sạch CC1 | Bước 7: Kết tinh phân đoạn được chọn sau bước 6 trong dung môi acetone thu được hợp chất sạch CC1 |
2.2.4. Các phương pháp phân tích
2.2.4.1. Phương pháp xác định sinh khối khô (CDW)
Giá trị CDW được xác định theo các bước: Các ống eppendorf 2 ml được đánh số thứ tự, sấy khô đến khối lượng không đổi và cân để xác định khối lượng ban đầu (Mo) của từng eppendorf. Mẫu nấm ở mỗi môi trường nuôi cấy được hút 1,5 ml và cho vào ống eppendorf, sau đó được li tâm 12000 v/p trong 5 phút. Dịch thể được loại bỏ và giữ lại sinh khối. 1,5 ml dịch nuôi cấy được bổ sung và li tâm. Sinh khối kết tủa được rửa bằng nước cất, sau đó được đông khô đến khối lượng không đổi. Khối lượng sau đông khô của ống và sinh khối là (M1). Mỗi mẫu nghiên cứu được lặp lại 3 lần. Khối lượng tế bào khô (CDW) được tính theo công thức:
CDW (g/l) = (M1 - Mo)/3*1000.
Li tâm toàn bộ dịch nuôi cấy, thu sinh khối, rửa bằng nước cất. Sau đó đông khô để phân tích COD.
2.2.4.2. Phương pháp định lượng COD có trong sinh khối nấm
Cân 10 mg sinh khối tế bào khô hòa trong 500 µl MeCN. Trộn đều hỗn hợp trong 10 phút. Sau đó ly tâm 10000 vòng/phút trong 5 phút, bỏ cặn, lấy phần dung dịch chứa COD phân tích. Hàm lượng COD tích lũy trong tế bào
được xác định bằng máy sắc kí lỏng hiệu năng cao (HPLC) sử dụng cột hypersil BDS-C18 và hệ dung môi acetonitrile-nước. Phân tích được thực hiện với tốc độ dòng 0,3 ml/phút với gradient nước-acetonitril, bắt đầu từ acetonitrile-nước (15:85) tới 100% acetonitril trong 40 phút, duy trì 100% acetonitril trong 5 phút, trước khi quay trở lại điều kiện bắt đầu trong 8 phút và cân bằng trong 5 phút [123]. Bước sóng đầu dò: 203 nm [161]. Beauvericin tinh sạch (Sigma - Mỹ) được sử dụng để xây dựng đồ thị chuẩn.

Hình 2.1. Đồ thị đường chuẩn xác định COD tích lũy theo phương pháp sắc ký lỏng
2.2.5. Phương pháp toán học
- Xử lý số liệu thống kê: Số liệu được nhập, xử lý, quản lý bằng các ứng dụng của phần mềm Microsoft Office Excel 2013 và các phân tích thống kê được thực hiện trên phần mềm SPSS 20 với ý nghĩa thống kê được xác định với giá trị P<0,05 theo 2 phía.
CHƯƠNG 3. KẾT QUẢ VÀ THẢO LUẬN
3.1. Đa dạng nấm ký sinh côn trùng phân lập từ mẫu thu ở Khu bảo tồn thiên nhiên Copia và Vườn quốc gia Xuân Sơn
3.1.1. Kết quả phân lập và nghiên cứu đặc điểm của nấm ký sinh côn trùng ở Khu bảo tồn thiên nhiên Copia và Vườn quốc gia Xuân Sơn
Các mẫu nấm ký sinh côn trùng (24 số mẫu) được thu thập ở Khu bảo tồn thiên nhiên Copia và Vườn quốc gia Xuân Sơn từ năm 2015 đến 2017, cụ thể:
Khu bảo tồn thiên nhiên Copia: 04 mẫu ký hiệu CPA1, CPA3, CPA5, CPA13V (đợt 1 - 8/2015); 06 mẫu ký hiệu CPA14V, CPA15, CPA16, CPA31, CPA40, CPA44 (đợt 2 - 12/2016).
Vườn quốc gia Xuân Sơn: 14 mẫu ký hiệu XS01, XS07, XS12, XS36, XS37, XS38, XS57, XS65, XS66, XS67, XS69, XS71, XS77, XS83 (đợt 3 - 5/2017).
Các mẫu ký chủ được định loại thuộc 05 bộ côn trùng Blattodea, Hemiptera, Coleoptera, Hymenoptera và Lepidoptera (GS. TS Trương Xuân Lam, NCS Nguyễn Đình Việt).
Môi trường Sabouraud bổ sung chloramphenicol được sử dụng để phân lập, thuần khiết các chủng nấm ký sinh côn trùng. Kết quả từ 24 mẫu ký chủ thuộc các bộ côn trùng Blattodea, Hemiptera, Coleoptera, Hymenoptera và Lepidoptera, 24 chủng nấm đã được phân lập, thuần khiết và bảo quản cho các nghiên cứu tiếp theo. Việc phân lập thuần khiết các chủng nấm ký sinh côn trùng rất có ý nghĩa trong công tác bảo tồn, lưu giữ và phát triển nguồn gen. Bên cạnh đó việc phân lập, làm chủ nguồn giống sẽ giúp chủ động trong việc nghiên cứu sản xuất và ứng dụng nấm ký sinh côn trùng trong các lĩnh vực như nông nghiệp, lâm nghiệm, y dược học…
3.1.1.1. Đặc đi m hình thái của các chủng nấm ký sinh côn trùng đ phân lập được
Mẫu CPA1 có trạng thái hữu tính, ký sinh trên ký chủ bộ Hymenoptera (Hình 3.1), thu được tại Khu BTTN Copia ở tọa độ 21,3100090N - 103,5922710E, độ cao 1405,5m, nơi có sinh cảnh rừng nguyên sinh.

Hình 3.1. Hình thái mẫu CPA1
a) Trạng thái hữu tính ngoài tự nhiên; b) Phần stroma; c) Quả th ; d) Khuẩn lạc nuôi cấy trên môi trường Sabouraud; e) Túi bào tử (Scale bar: a-1cm, b-
1000µm c-100µm, d-1cm, e-50µm)
Phần stroma phát sinh từ phần khe cổ của kiến, có dạng hình trụ, màu vàng cam, kích thước 7cm (Hình 3.1a), phía đỉnh phình to kích thước 0.2cm x 0.5cm là nơi chứa quả thể hữu tính (Hình 3.1b). Quả thể hữu tính nằm chìm hoàn toàn trong phần stroma, có dạng hình quả đào, kích thước 300-400µm, túi bào tử hình trụ, có thành mỏng, thuôn dài kích thước 217.24µm x 3.64µm, có mũ dạng tròn kích thước 3µm-3,5µm (Hình 3.1e). Khi nuôi cấy trên môi
trường sabouraud hệ sợi có màu trắng (Hình 3.1d). Đặc điểm hình thái của mẫu CPA1 là đặc điểm của chi Ophiocordyceps.
Mẫu CPA3 có trạng thái vô tính, ký sinh trên ký chủ bộ Coleoptera (Hình 3.2), thu được tại Khu BTTN Copia ở tọa độ 21,3101290N - 103,5932710E, độ cao 1455,5m, nơi có sinh cảnh rừng nguyên sinh.
Hình 3.2. Hình thái mẫu CPA3
a) Phần stroma; b) Khuẩn lạc nuôi cấy trên môi trường Sabouraud; c) Bào tử và cuống sinh bào tử (Scale bar: a- 1cm, b- 1cm, c- 10µm)
Phần stroma phát sinh từ phần đầu của ký chủ, có dạng hình trụ, màu vàng cam, kích thước 13cm (Hình 3.2a). Hình thái hệ sợi khi nuôi cấy trên môi trường sabouraud có màu trắng (Hình 3.2b), bào tử có dạng hình tròn kích thước 2-3µm, thể bình thuôn dài thu hẹp ở phía cổ, kích thước thể bình 5-7µm (Hình 3.2c). Đặc điểm hình thái của mẫu CPA3 là đặc điểm của chi Cordyceps.
Mẫu CPA5 có trạng thái vô tính, ký sinh trên ký chủ bộ Coleoptera (Hình 3.3), thu được tại Khu BTTN Copia ở ở tọa độ 21,312390N - 103,5924710E, độ cao 1465,5m, nơi có sinh cảnh trảng cỏ của rừng phục hồi sau cháy.
Trạng thái nấm trên bề mặt côn trùng trông như bụi phấn, tơi xốp, rời rạc phủ quanh phần bụng, đầu, các khớp của kí chủ (Hình 3.3a). Cuống sinh bào
tử ngắn, nhỏ, thuôn và mang các bào tử tròn. Các bào tử có kích thước nhỏ 2- 3,0µm (Hình 3.3b). Hệ sợi nuôi cấy trên môi trường Sabouraud có màu trắng mịn (Hình 3.3c). Cuống sinh bào tử của nấm trên môi trường nhân tạo dạng phân nhánh, thể bình thuôn dài (5-7µm), với các bào tử hình cầu, kích thước như các bào tử trên mẫu tự nhiên 2-3 µm (Hình 3.3d). Chỉ với đặc điểm trạng thái vô tính, rất khó để định loại mẫu nấm thu được. Đặc điểm hình thái của mẫu CPA5 rất giống với đặc điểm của chi Beauveria.

Hình 3.3. Hình thái mẫu CPA5
a) Trạng thái ngoài tự nhiên; b) Bào tử; c) Hệ sợi trên môi trường Sabouraud;
d) Cuống sinh bào tử (Scale bar: a- 0.1cm, b - 5µm, c-1cm, d-10µm)
Mẫu CPA13V có trạng thái hữu tính, ký sinh trên ký chủ bộ Lepidoptera (Hình 3.4), thu được tại Khu BTTN Copia ở tọa độ 21,3100690N - 103,5923710E, độ cao 1005,5m, nơi có sinh cảnh rừng nguyên sinh.
Kích thước ký chủ 4cm, phần stroma có kích thước từ 2-2,5cm, màu vàng, nhạt, mềm (Hình 3.4a). Quả thể có dạng hình quả đào, gắn nửa nổi nửa chìm trên bề mặt chất nền, kích thước quả thể lớn 300-500µm (Hình 3.4b). Túi bào tử dạng hình trụ, kích thước 150-250µm, đỉnh túi có mũ dạng tròn kích thước 5-6µm, không bắt màu với thuốc nhuộm Melzer‟s (J-) (Hình 3.4c). Khi nuôi
cấy trên môi trường Sabouraud có màu trắng, sau 1 tuần nuôi cấy xuất hiện các cụm bào tử đối xứng quanh 1 trục, hình tròn, có kích thước 2-3mµ, thể bình có kích thước 7.81µ x 2.5µm (Hình 3.4d, 3.4e). Đặc điểm hình thái của mẫu nghiên cứu rất gần với các đặc điểm chi Cordyceps.

Hình 3.4. Hình thái mẫu CPA13V
a) Trạng thái ngoài tự nhiên; b) Quả th ; c) Túi bào tử; d) Khuẩn lạc nuôi cấy trên môi trường Sabouraud; e) Bào tử và cuống sinh bào tử (Scale bar: a-
1cm, b- 100µm, c-10µm, d-1cm, e-10µm)
Mẫu CPA14V có trạng thái vô tính, ký sinh trên ký chủ bộ Blattodea (Hình 3.5), thu được tại Khu BTTN Copia ở ở tọa độ 21,3170690N - 103,59337450E, độ cao 1100m, nơi có sinh cảnh rừng nguyên sinh.






